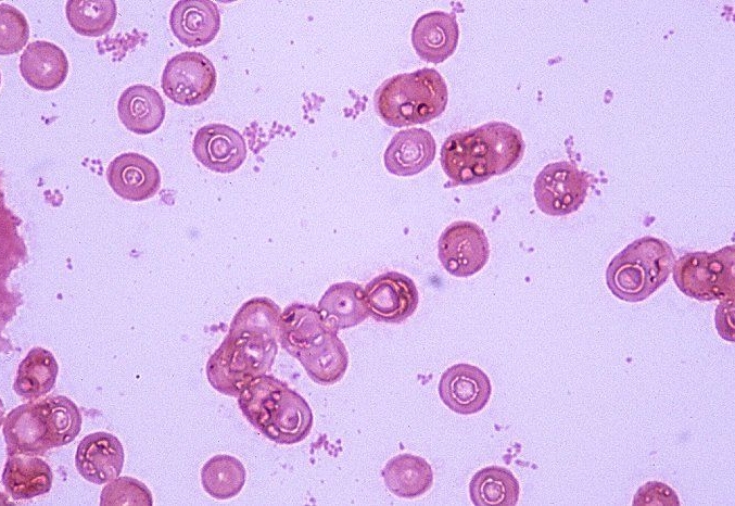

Шанкроїд, або м'який шанкер реєструється практично у всіх країнах світу і в ряді регіонів значно переважає інші захворювання, які передаються статевим шляхом. Ця венерична інфекція проявляється гостро та болісно, розвивається досить швидко та типово, часто поєднується з ВІЛ, сифілісом і навіть із генітальним герпесом, що може ускладнити діагностику захворювання. М'який шанкр однаково часто і сильно вражає чоловіків і жінок, але найчастіше чоловіки отримують при цьому гостре прояв хвороби, а жінки – жінки; тривале і абсолютно безсимптомне носійство.
Особливості поширення м'якого шанкра та симптоми хвороби
Вперше збудник хвороби під назвою м'який шанкер – паличка Haemophilus ducreyi – було описано різними дослідниками ще наприкінці 19 століття. Ці стрептобацили цілком стійкі до хімічних речовин та низьких температур, але якщо впливати на них нагріванням і тим більше кип'ятінням, вони швидко гинуть.
Розповсюджується ця венерична інфекція переважно статевим шляхом, хоча відомі ймовірні випадки позастатевого зараження медичних працівників. Вигляд статевого контакту не має значення, ймовірність зараження м'яким шанкром після першого контакту становить близько 50%.
Шанкроїд має дуже короткий інкубаційний період – близько тижня, але симптоми зараження можуть проявитися навіть через день чи два після незахищеного статевого контакту. У місці застосування стрептобацили з'являється яскраво-червона набрякова пляма. У центрі такої плями формується спершу вузлик, а потім на його місці - бульбашка з гнійним вмістом. Власне шанкр, тобто хвороблива виразка розвивається через кілька днів і має неправильну форму, причому виразка швидко розростається і в ширину, і в глибину. Виразка м'яка, але дуже болісна, кровоточить, має запалений віночок і гнійний наліт з кров'ю на самому дні. Гнійне відокремлюване з виразки, потрапляючи випадково на навколишні тканини, провокує появу нових дрібних виразок по периферії, які можуть зливатися в одну велику виразку, що повзу.
Зазвичай виразки м'якого шанкеру розташовуються на статевих органах, рідше в області ануса або на слизовій порожнині рота. Позастатеві прояви м'якого шанкеру (наприклад, у медиків) можуть зустрітися на долонях, пальцях рук, іноді хворі самі розносять інфекцію з уражених ділянок по всьому тілу.
Протягом м'якого шанкеру та можливі ускладнення
Нові виразкові елементи при м'якому шанкрі продовжують формуватися протягом приблизно 4 тижнів, далі вони потроху починають гоїтися, формуючи невеликі рубці. Без своєчасного адекватного лікування м'який шанкер може ускладнитися ураженням судин, лімфатичних вузлів, розвитком фімозу та парафімозу.
Серед ускладнень м'якого шанкеру можливе також поширення інфекції по периферії - зі статевих органів перенесення виразок на стегна, промежину, лобок. Можливий і розвиток венеричної інфекції вглиб – це її гангренозний різновид, який небезпечний септичними явищами, оголенням і руйнуванням кавернозних тіл, сильними кровотечами і тривалим прогресуючим перебігом, коли уражаються великі зони.

Як правильно лікувати м'який шанкер
Головна особливість м'якого шанкеру в тому, що, на відміну від більшості венеричних інфекцій, це захворювання легко піддається лікуванню антибіотиками або сульфаніламідами. Причому, якщо терапія розпочата на початковому етапі захворювання, немає ускладнюючих факторів, то одужання пацієнта. настає протягом приблизно 10 днів.
Переважне застосування антибактеріальних препаратів, дія яких спрямована і на стрептобацил, і на збудника сифілісу. Паралельно використовуються антибіотики місцевої дії для полегшення клінічних симптомів, а також імуномодулюючі препарати. У занедбаних та ускладнених випадках м'якого шанкеру може знадобитися хірургічне втручання.
Організм людини, на жаль, не здатний виробляти імунітет проти стрептобацил, тому залишається можливість повторного зараження пацієнта. За раннього початку лікування прогноз сприятливий.

Додати коментар